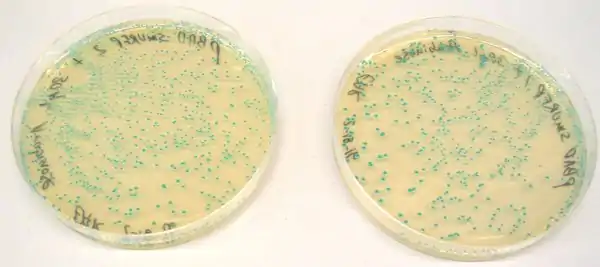

.gif)
Small ultra red fluorescent protein (smURFP) is a class of far-red fluorescent protein evolved from a cyanobacterial (Trichodesmium erythraeum) phycobiliprotein, α-allophycocyanin.[1][2][3] Native α-allophycocyanin requires an exogenous protein, known as a lyase, to attach the chromophore, phycocyanobilin. Phycocyanobilin is not present in mammalian cells. smURFP was evolved to covalently attach phycocyanobilin without a lyase and fluoresce, covalently attach biliverdin (ubiquitous to mammalian cells) and fluoresce, blue-shift fluorescence to match the organic fluorophore, Cy5, and not inhibit E. coli growth. smURFP was found after 12 rounds of random mutagenesis and manually screening 10,000,000 bacterial colonies.
Properties
smURFP is a homodimer with absorption and emission maximum of 642 nm and 670 nm, respectively. A tandem dimer smURFP (TDsmURFP) was created and has similar properties to smURFP. smURFP is extremely stable with a protein degradation half-life of 17 hour and 33 hour without and with chromophore (biliverdin), respectively. This is comparable to the jellyfish-derived enhanced green fluorescent protein (eGFP) protein degradation half-life of 24 hour.[4] smURFP is extremely photostable and out performs mCherry[5] and tdTomato[5] in living cells. Single-molecule smURFPs emit twice as many photons before photobleaching than small-molecule dyes AlexaFluor647 and Cyanine5.[6] The extinction coefficient (180,000 M−1 cm−1) of smURFP is extremely large and has a modest quantum yield (0.18), which makes it comparable biophysical brightness to eGFP and ~2-fold brighter than most red or far-red fluorescent proteins derived from coral. smURFP has the largest two-photon cross-section measured for a fluorescent protein. There are two peak cross-sections of 1,060 and 60 GM at 820 and 1,196 nm, respectively.[7] Despite being a homodimer, all tested N- and C- terminal fusions show correct cellular localization, including the difficult fusion to α-tubulin and Lamin B1 (Figure).[1] smURFP is named after the Smurfs, due to its light blue appearance in white light.[1]
An Excel sheet of the smURFP absorbance, excitation, and emission spectra can be downloaded here. The crystal structure of the smURFP (PDB: 7UQA)was determined and used to understand the directed evolution. smURFP was also compared to the parental α-allophycocyanin.[8] The crystal structure of a smURFP mutant (PDB: 6FZN) was published in Fuenzalida-Werner et al.[9] The mutants show significantly larger chromophore pockets and protein volume, which results in diminished quantum yield.[10] A 2020 review discusses recent applications of smURFP as a genetically encoded or exogenous probe for in vivo imaging and discusses problems with biliverdin availability.[11]

smURFP used as nanoparticles, exogenous probes, and in vitro assays
Free smURFP is 2-3 nm in diameter. smURFP nanoparticles of ~10-14 nm diameter can be synthesized in an oil and water emulsion and remain fluorescent. These fluorescent protein nanoparticles are stable in living mice and useful for non-invasive tumor fluorescence imaging.[12]
Purified smURFP survives ultrasound and fixation to allow fluorescence imaging of macromolecule delivery by ultrasound into corneas.[13]
Free smURFP, purified protein and not genetically encoded, can be encapsulated into viruses and used for non-invasive, fluorescence imaging of biodistribution in living mice.[14][15][16]
smURFP covalently attaches biliverdin to turn on fluorescence and is inherently a biliverdin sensor. Researchers showed purified smURFP has a limit of detection of 0.4 nM for biliverdin in human serum.[17] smURFP allows for the creation of in vitro assays to detect enzyme activity. An assay was developed for thrombin with a detection range of 1.07 aM–0.01 mM and a limit of detection of 0.2 aM.[18]
Tandem dimer smURFP (TDsmURFP) was used as an exogenous fluorescent marker to label the seven-transmembrane receptor Smoothened (SMO). TDsmURFP was purified from E. coli and attached to SMO by sortase-mediated conjugation for fluorescence-activated cell sorting (FACS).[19] This novel, exogenous fluorescent protein labeling avoids screening multiple protein insertion sites, organic solvents, and chemical reactions that misfold, inactivate, or degrade proteins.
smURFP is a self-labeling protein

The small Ultra-Red Fluorescent Protein (smURFP) is a self-labeling protein like Halo-, SNAP-, and CLIP-tags. The smURFP-tag accepts a biliverdin substrate modified on a carboxylate with a polyethylene glycol (PEG) linker to the cargo molecule. Unlike the Halo-, SNAP-, and CLIP-tags that use the substrate to only covalently attach the cargo molecule, biliverdin is fluorogenic, and fluorescence is turned "on" with covalent attachment to the smURFP-tag to allow far-red fluorescence tracking of cargo molecule in living cells. Biliverdin also quenches fluorescein cargo to allow for imaging without substrate removal. Biliverdin modification on a single carboxylate creates a neutral molecule that passes the outer and nuclear membrane of mammalian cells.[21]
Chromophore availability in cells and mice

Despite showing comparable biophysical brightness to eGFP when purified protein was normalized, this was not seen in living cells. This suggested there was not enough chromophore (biliverdin) within cells. Addition of biliverdin increased fluorescence, but smURFP with biliverdin was not comparable to eGFP. Biliverdin has two carboxylates at neutral pH and this is inhibiting cellular entry. Biliverdin dimethyl ester is a more hydrophobic analog and readily crosses the cellular membrane. smURFP with biliverdin dimethyl ester shows comparable fluorescence to eGFP in cells and is brighter than bacterial phytochrome fluorescent proteins.
The free chromophore can be differentiated from chromophore attached to smURFP by fluorescence lifetime imaging (FLIM) in living cells. Free biliverdin dimethyl ester (BVMe2) has a fluorescence lifetime of 0.586 ns, while BVMe2 attached to smURFP has a fluorescence lifetime of 1.27 ns.[22]

In mice, smURFP fluorescence is visible in HT1080 tumor xenografts without exogenous biliverdin, but fluorescence is less than coral-derived red fluorescent proteins, mCherry[5] and mCardinal.[23] Visible fluorescence is not always usable fluorescence and fluorescent proteins should always be compared to other useful, genetically encoded fluorescent proteins. Intravenous injection of exogenous biliverdin or biliverdin dimethyl ester does not increase fluorescence of smURFP expressed in tumors after 1 to 24 hours. Mass spectrometry showed that the ester groups were rapidly removed from biliverdin dimethyl ester. Addition of 25 μM biliverdin or biliverdin dimethyl ester dramatically increased fluorescence of excised tumors and smURFP is present without chromophore. Further research is necessary to optimize chromophore availability in mice to obtain fluorescence comparable or greater than coral-derived red fluorescent proteins.
Adding chromophore to cells
Biliverdin dimethyl ester, biliverdin, and phycocyanobilin are commercially available from Frontier Scientific. Biliverdin dimethyl ester, biliverdin, or phycocyanobilin is dissolved in DMSO at a concentration of 5 mM. The solution is very dark and pipette vigorously to ensure all is dissolved. Biliverdin dimethyl ester is not soluble in common buffers, including phosphate buffered saline (PBS) or Hank's balanced salt solution (HBSS). Add 1-5 μM biliverdin dimethyl ester in media or buffer containing 10% fetal bovine serum (FBS). Add 25 μM biliverdin (not as membrane permeant) to cells. Biliverdin does not saturate the smURFP sites and does not achieve maximum fluorescence intensity. Biliverdin dimethyl ester should be used to get maximum fluorescence intensity. Incubate smURFP with chromophore for as long as possible to increase protein accumulation caused by enhanced protein stability with chromophore. Leave chromophore for a minimum of 3 hours and 24 h is recommended. Remove chromophore, wash with media containing 10% FBS, and image in media lacking phenol red or imaging buffer.
smURFP genetically encoded biosensors

Kinase FRET sensor. smURFP is a useful acceptor for many red fluorescent proteins due to spectral overlap. A rationally designed red fluorescent protein, stagRFP, allows for easier creation of FRET sensors. stagRFP is a useful FRET donor to the far-red acceptor smURFP and an ERK kinase FRET reporter was created with an average response of ~15%. The new sensor allowed for simultaneous visualization of three kinases, Src, Akt, ERK, in a single cell.[24]
Fluorescently imaging the cell cycle. Pioneering work by Atsushi Miyawaki and coworkers developed the fluorescent ubiquitination-based cell cycle indicator (FUCCI), which enables fluorescence imaging of the cell cycle. Originally, a green fluorescent protein, mAG, was fused to hGem(1/110) and an orange fluorescent protein (mKO2) was fused to hCdt1(30/120). Note, these fusions are fragments that contain a nuclear localization signal and ubiquitination sites for degradation, but are not functional proteins. The green fluorescent protein is made during the S, G2, or M phase and degraded during the G0 or G1 phase, while the orange fluorescent protein is made during the G0 or G1 phase and destroyed during the S, G2, or M phase.[25] A far-red and near-infrared FUCCI was developed using a cyanobacteria-derived fluorescent protein (smURFP) and a bacteriophytochrome-derived fluorescent protein (movie found at this link).[1]
References
- 1 2 3 4 Rodriguez, Erik A.; Tran, Geraldine N.; Gross, Larry A.; Crisp, Jessica L.; Shu, Xiaokun; Lin, John Y.; Tsien, Roger Y. (2016-08-01). "A far-red fluorescent protein evolved from a cyanobacterial phycobiliprotein". Nature Methods. 13 (9): 763–9. doi:10.1038/nmeth.3935. ISSN 1548-7105. PMC 5007177. PMID 27479328.
- ↑ US Patent 20180201655A1, Rodriguez, Erik A.; Tran, Geraldine N. & Lin, John Y. et al., "Allophycocyanin alpha-subunit evolved labeling proteins (smURFPs).", issued 2019-12-10
- ↑ Mattson, Sara; Tran, Geraldine N.; Rodriguez, Erik A. (2023), Sharma, Mayank (ed.), "Directed Evolution of Fluorescent Proteins in Bacteria", Fluorescent Proteins, New York, NY: Springer US, vol. 2564, pp. 75–97, doi:10.1007/978-1-0716-2667-2_4, ISBN 978-1-0716-2666-5, PMID 36107338, retrieved 2022-09-16
- ↑ Stack, J. H.; Whitney, M.; Rodems, S. M.; Pollok, B. A. (2000-12-01). "A ubiquitin-based tagging system for controlled modulation of protein stability". Nature Biotechnology. 18 (12): 1298–1302. doi:10.1038/82422. ISSN 1087-0156. PMID 11101811. S2CID 23741831.
- 1 2 3 Shaner, Nathan C.; Campbell, Robert E.; Steinbach, Paul A.; Giepmans, Ben N. G.; Palmer, Amy E.; Tsien, Roger Y. (2004-12-01). "Improved monomeric red, orange and yellow fluorescent proteins derived from Discosoma sp. red fluorescent protein". Nature Biotechnology. 22 (12): 1567–1572. doi:10.1038/nbt1037. ISSN 1087-0156. PMID 15558047. S2CID 205272166.
- ↑ Maiti, Atanu; Buffalo, Cosmo Z.; Saurabh, Saumya; Montecinos-Franjola, Felipe; Hachey, Justin S.; Conlon, William J.; Tran, Geraldine N.; Hassan, Bakar; Walters, Kylie J.; Drobizhev, Mikhail; Moerner, W. E.; Ghosh, Partho; Matsuo, Hiroshi; Tsien, Roger Y.; Lin, John Y. (2023-07-12). "Structural and photophysical characterization of the small ultra-red fluorescent protein". Nature Communications. 14 (1): 4155. doi:10.1038/s41467-023-39776-9. ISSN 2041-1723. PMC 10338489.
- ↑ Maiti, Atanu; Buffalo, Cosmo Z.; Saurabh, Saumya; Montecinos-Franjola, Felipe; Hachey, Justin S.; Conlon, William J.; Tran, Geraldine N.; Hassan, Bakar; Walters, Kylie J.; Drobizhev, Mikhail; Moerner, W. E.; Ghosh, Partho; Matsuo, Hiroshi; Tsien, Roger Y.; Lin, John Y. (2023-07-12). "Structural and photophysical characterization of the small ultra-red fluorescent protein". Nature Communications. 14 (1): 4155. doi:10.1038/s41467-023-39776-9. ISSN 2041-1723. PMC 10338489.
- ↑ Maiti, Atanu; Buffalo, Cosmo Z.; Saurabh, Saumya; Montecinos-Franjola, Felipe; Hachey, Justin S.; Conlon, William J.; Tran, Geraldine N.; Hassan, Bakar; Walters, Kylie J.; Drobizhev, Mikhail; Moerner, W. E.; Ghosh, Partho; Matsuo, Hiroshi; Tsien, Roger Y.; Lin, John Y. (2023-07-12). "Structural and photophysical characterization of the small ultra-red fluorescent protein". Nature Communications. 14 (1): 4155. doi:10.1038/s41467-023-39776-9. ISSN 2041-1723. PMC 10338489.
- ↑ Fuenzalida-Werner, JP; Janowski, R; Mishra, K; Weidenfeld, I; Niessing, D; Ntziachristos, V; Stiel, AC (December 2018). "Crystal structure of a biliverdin-bound phycobiliprotein: Interdependence of oligomerization and chromophorylation". Journal of Structural Biology. 204 (3): 519–522. doi:10.1016/j.jsb.2018.09.013. PMID 30287387. S2CID 52919137.
- ↑ Maiti, Atanu; Buffalo, Cosmo Z.; Saurabh, Saumya; Montecinos-Franjola, Felipe; Hachey, Justin S.; Conlon, William J.; Tran, Geraldine N.; Hassan, Bakar; Walters, Kylie J.; Drobizhev, Mikhail; Moerner, W. E.; Ghosh, Partho; Matsuo, Hiroshi; Tsien, Roger Y.; Lin, John Y. (2023-07-12). "Structural and photophysical characterization of the small ultra-red fluorescent protein". Nature Communications. 14 (1): 4155. doi:10.1038/s41467-023-39776-9. ISSN 2041-1723. PMC 10338489.
- ↑ Montecinos-Franjola, Felipe; Lin, John Y.; Rodriguez, Erik A. (2020-11-16). "Fluorescent proteins for in vivo imaging, where's the biliverdin?". Biochemical Society Transactions. 48 (6): 2657–2667. doi:10.1042/BST20200444. ISSN 0300-5127. PMID 33196077. S2CID 226971864.
- ↑ An, Feifei; Chen, Nandi; Conlon, William J.; Hachey, Justin S.; Xin, Jingqi; Aras, Omer; Rodriguez, Erik A.; Ting, Richard (February 2020). "Small ultra-red fluorescent protein nanoparticles as exogenous probes for noninvasive tumor imaging in vivo". International Journal of Biological Macromolecules. 153: 100–106. doi:10.1016/j.ijbiomac.2020.02.253. PMC 7493049. PMID 32105698.
- ↑ Almogbil, Hanaa H.; Montecinos-Franjola, Felipe; Daszynski, Camille; Conlon, William J.; Hachey, Justin S.; Corazza, Giavanna; Rodriguez, Erik A.; Zderic, Vesna (2022-08-01). "Therapeutic Ultrasound for Topical Corneal Delivery of Macromolecules". Translational Vision Science & Technology. 11 (8): 23. doi:10.1167/tvst.11.8.23. ISSN 2164-2591. PMC 9424970. PMID 35998058. S2CID 251743679.
- ↑ Herbert, Fabian C.; Brohlin, Olivia; Galbraith, Tyler; Benjamin, Candace; Reyes, Cesar A.; Luzuriaga, Michael A.; Shahrivarkevishahi, Arezoo; Gassensmith, Jeremiah J. (2020-04-03). "Supramolecular Encapsulation of Small-Ultra Red Fluorescent Proteins in Virus-Like Nanoparticles for Non-Invasive In Vivo Imaging Agents". doi:10.26434/chemrxiv.12067851.v1. S2CID 216595590.
{{cite journal}}: Cite journal requires|journal=(help) - ↑ Herbert, Fabian C.; Brohlin, Olivia R.; Galbraith, Tyler; Benjamin, Candace; Reyes, Cesar A.; Luzuriaga, Michael A.; Shahrivarkevishahi, Arezoo; Gassensmith, Jeremiah J. (2020-05-07). "Supramolecular Encapsulation of Small-Ultrared Fluorescent Proteins in Virus-Like Nanoparticles for Noninvasive In Vivo Imaging Agents". Bioconjugate Chemistry. 31 (5): 1529–1536. doi:10.1021/acs.bioconjchem.0c00190. ISSN 1043-1802. PMID 32343135.
- ↑ Trashi, Ikeda; Durbacz, Mateusz Z.; Trashi, Orikeda; Wijesundara, Yalini H.; Ehrman, Ryanne N.; Chiev, Alyssa C.; Darwin, Cary B.; Herbert, Fabian C.; Gadhvi, Jashkaran; Nisco, Nicole J. De; Nielsen, Steven O.; Gassensmith, Jeremiah J. (2023-04-25). "Self-assembly of a fluorescent virus-like particle for imaging in tissues with high autofluorescence". Journal of Materials Chemistry B. doi:10.1039/D3TB00469D. ISSN 2050-7518.
- ↑ Zhu, Xiaqing; Feng, Shuren; Jiang, Zhongyi; Zhang, Huayue; Wang, Yanyan; Yang, Haitao; Wang, Zefang (August 2021). "An ultra-red fluorescent biosensor for highly sensitive and rapid detection of biliverdin". Analytica Chimica Acta. 1174: 338709. doi:10.1016/j.aca.2021.338709. PMID 34247733. S2CID 235796133.
- ↑ Zhang, Huayue; Yang, Lu; Zhu, Xiaqing; Wang, Yanyan; Yang, Haitao; Wang, Zefang (2020-05-13). "A Rapid and Ultrasensitive Thrombin Biosensor Based on a Rationally Designed Trifunctional Protein". Advanced Healthcare Materials. 9 (12): 2000364. doi:10.1002/adhm.202000364. ISSN 2192-2640. PMID 32406199. S2CID 218633091.
- ↑ Deshpande, Ishan; Liang, Jiahao; Hedeen, Danielle; Roberts, Kelsey J.; Zhang, Yunxiao; Ha, Betty; Latorraca, Naomi R.; Faust, Bryan; Dror, Ron O.; Beachy, Philip A.; Myers, Benjamin R. (July 2019). "Smoothened stimulation by membrane sterols drives Hedgehog pathway activity". Nature. 571 (7764): 284–288. doi:10.1038/s41586-019-1355-4. ISSN 1476-4687. PMC 6709672. PMID 31263273.
- ↑ Machado, John-Hanson; Ting, Richard; Lin, John Y.; Rodriguez, Erik A. (2021). "A self-labeling protein based on the small ultra-red fluorescent protein, smURFP". RSC Chemical Biology. 2 (4): 1221–1226. doi:10.1039/D1CB00127B. ISSN 2633-0679. PMC 8341759. PMID 34458834.
- ↑ Machado, John-Hanson; Ting, Richard; Lin, John Y.; Rodriguez, Erik A. (2021). "A self-labeling protein based on the small ultra-red fluorescent protein, smURFP". RSC Chemical Biology. 2 (4): 1221–1226. doi:10.1039/D1CB00127B. ISSN 2633-0679. PMC 8341759. PMID 34458834.
- ↑ Maiti, Atanu; Buffalo, Cosmo Z.; Saurabh, Saumya; Montecinos-Franjola, Felipe; Hachey, Justin S.; Conlon, William J.; Tran, Geraldine N.; Hassan, Bakar; Walters, Kylie J.; Drobizhev, Mikhail; Moerner, W. E.; Ghosh, Partho; Matsuo, Hiroshi; Tsien, Roger Y.; Lin, John Y. (2023-07-12). "Structural and photophysical characterization of the small ultra-red fluorescent protein". Nature Communications. 14 (1): 4155. doi:10.1038/s41467-023-39776-9. ISSN 2041-1723. PMC 10338489.
- ↑ Chu, Jun; Haynes, Russell D; Corbel, Stéphane Y; Li, Pengpeng; González-González, Emilio; Burg, John S; Ataie, Niloufar J; Lam, Amy J; Cranfill, Paula J (2014). "Non-invasive intravital imaging of cellular differentiation with a bright red-excitable fluorescent protein". Nature Methods. 11 (5): 572–578. doi:10.1038/nmeth.2888. PMC 4008650. PMID 24633408.
- ↑ Mo, Gary C. H.; Posner, Clara; Rodriguez, Erik A.; Sun, Tengqian; Zhang, Jin (December 2020). "A rationally enhanced red fluorescent protein expands the utility of FRET biosensors". Nature Communications. 11 (1): 1848. Bibcode:2020NatCo..11.1848M. doi:10.1038/s41467-020-15687-x. ISSN 2041-1723. PMC 7160135. PMID 32296061.
- ↑ Sakaue-Sawano, Asako; Kurokawa, Hiroshi; Morimura, Toshifumi; Hanyu, Aki; Hama, Hiroshi; Osawa, Hatsuki; Kashiwagi, Saori; Fukami, Kiyoko; Miyata, Takaki (2008-02-08). "Visualizing spatiotemporal dynamics of multicellular cell-cycle progression". Cell. 132 (3): 487–498. doi:10.1016/j.cell.2007.12.033. ISSN 1097-4172. PMID 18267078. S2CID 15704902.
External links
- SmURFP KX449134 & TDsmURFP, KX449135 - GenBank/EMBL/DDBJ Accession Codes
- FPbase entry
- Obtain Plasmid DNA at Addgene (Non-profit organization for sharing DNA.)
- 7UQA smURFP cyrstal structure.